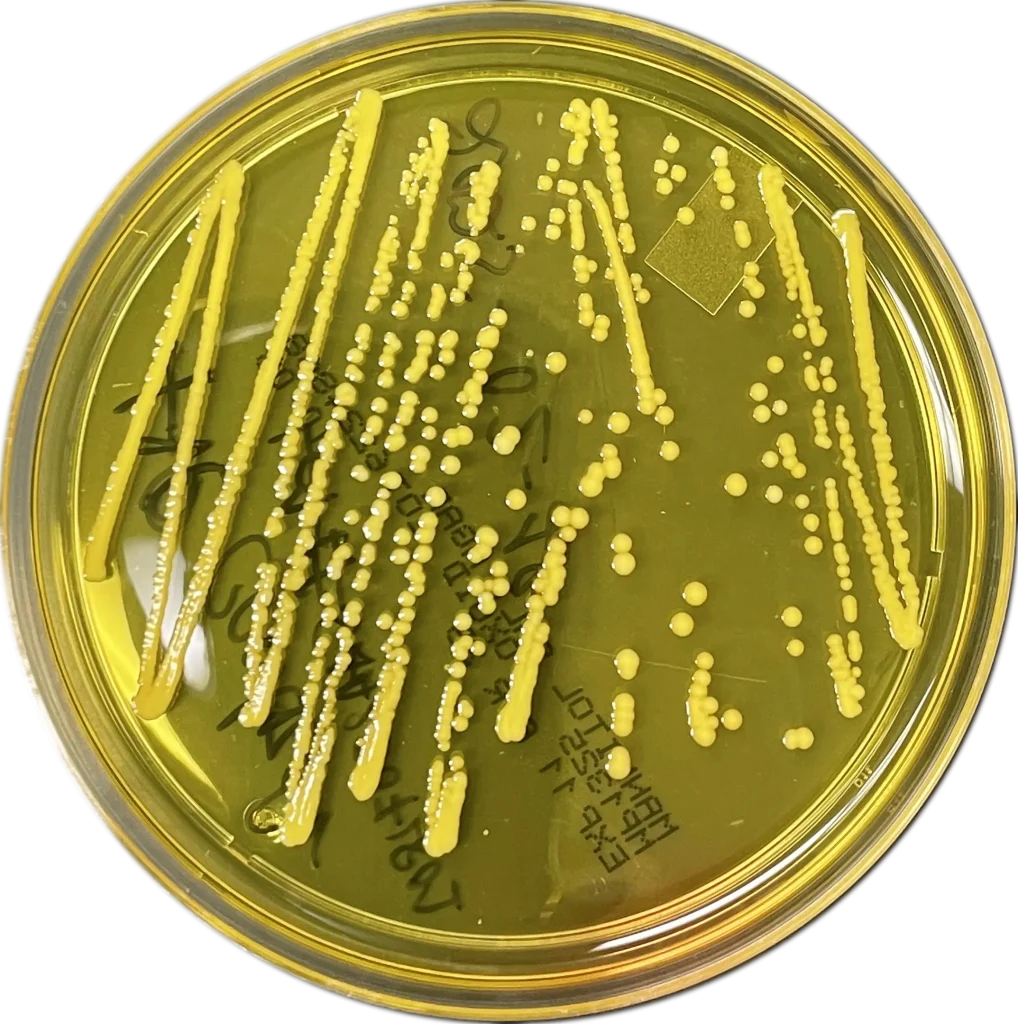

Services
From idea to prototype with scientific precision.
Lifelore Pathways is a full-spectrum platform supporting early-stage microbial development.
Whether you’re validating a new strain, prototyping a fermentation process, or preparing for scale-up, our Montreal-based facility offers the tools, infrastructure, and scientific guidance to accelerate your progress.
Services
What we offer
We support microbial innovation from lab to pilot to industrial readiness.
Project design & scientific consulting
Custom project design and experimental planning
Feasibility assessment and regulatory insight
Early-stage IP and data strategy guidance
Strain development & optimization
Screening of bacteria, fungi, and phages
Strain adaptation to environmental or process-specific constraints
Optimization for productivity and robustness
Fermentation capabilities
Bench-scale fermentation (5–10 L)
Pilot-scale batches (25–250 L)
Industrial-scale production (up to 2000 L)
Formats: broth and dry powder
Bacteria, fungi, and cell-free metabolites
Downstream processing & purification
Cell and metabolite separation
Concentration, filtration (TFF), and drying (spray/freeze)
Press filters, centrifugation (disc stack, tubular, high-speed)
Analytical & biological services
Microbial identification & genomics: microbial isolation, VBNC detection, metagenomics, genome sequencing, PCR, RT-qPCR
Strain & protein profiling: probiotic screening, enzyme and crystal protein activity, molecular cloning, bioinformatics
Synergistic systems: co-culture optimization and interaction analysis
Metabolite analysis: nutrients, contaminants, metabolic fingerprints
Product safety & regulatory readiness
Microbial safety assessment
Stability testing
GMP-readiness evaluation
All services are delivered in our GMP-compatible facility in Montreal.
Services
Our equipment
Our infrastructure bridges R&D and industrial needs. From strain screening to scaled fermentation and precision analytics, we’ve got you covered.
Fermentation
5L to 2000L, including Celltainer CT2
Drying
Spray and freeze, lab to industrial scale
Filtration
Press, ultrafiltration (TFF), CIP system
Analytics
PCR, microscopy, electrophoresis, bioinformatics tools
Cold chain
-80 °C, -20 °C, walk-in freezer
Molecular tools
Electroporation, genome workstations
